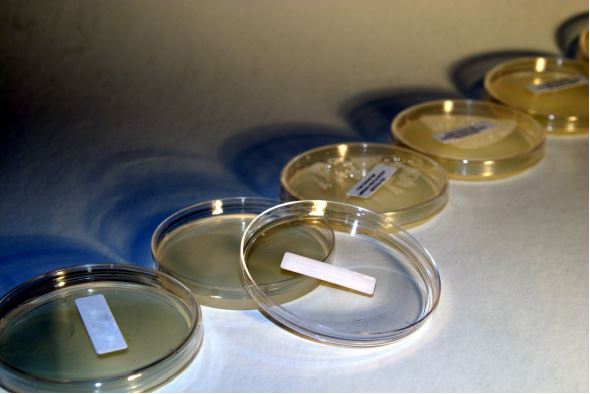

Anaerobic antibiotic sensitivities are not routinely performed in diagnostic laboratories because testing is difficult, expensive, and routine techniques as used for aerobic organisms are often inaccurate. Fortunately, antibiotic resistance by anaerobes remains relatively low (but not non-existent) and makes the need for sensitivity testing less critical compared to aerobic bacteria.
Anaerobic bacteria are typically sensitive to metronidazole and are often sensitive to amoxycillin/clavulanate.